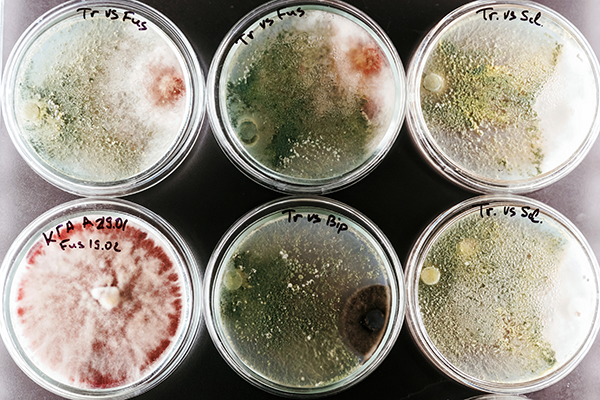
Petri Dishes of Microbial Growth

Achieving consistent, high-density microbial growth is one of the biggest challenges in bioprocess development, fermentation optimization, and microbiology research. Whether the goal is to express recombinant proteins, characterize strain behaviour, or run long-term evolution studies, researchers need cultures that remain stable, predictable, and easy to control.
Yet traditional batch cultivation often works against these needs. Nutrient levels change, metabolic states shift, and culture behaviour becomes less reliable the longer a run continues, especially at high biomass.
This is precisely why automated cell density-controlled continuous cultivation, referred to here as turbidostat operation, has gained renewed interest across biotechnology. By automatically maintaining a constant cell density, creating and operating a turbidostat enables scientists to generate reproducible data, sustain high-growth conditions, and reduce the time spent and human error associated with manually adjusting cultures.
In this guide, we break down how turbidostats work, why they matter, and how modern platforms, such as the H.E.L BioXplorer platforms, make high-density continuous cultivation more accessible than ever.
What Is a Turbidostat and Why Is It Useful?
H.E.L's BioVIS Probes with Automation Software
A turbidostat is a type of continuous bioreactor that uses real-time turbidity or optical density (OD) measurements coupled to automated liquid feeding and removal, which control dilution rates, to regulate culture growth. When the biomass rises above a set threshold, the system automatically:
- Adds fresh medium
- Removes the excess culture
- Returns the biomass to the target level
This creates a steady-state environment, where microbial cells grow continuously under stable conditions.
Key Advantages of Turbidostat Cultivation:
- Stable biomass for long or comparative experiments
- Consistent cell physiology
- Improved productivity in high-density systems
- Fewer manual interventions
- Better reproducibility across runs
- Useful for strain development, bioproduction, and metabolic engineering
These benefits make turbidostats particularly valuable anywhere precision and consistency matter.
Why High-Density Cultivation Is So Challenging
Growing cultures to high density and maintaining their stability is notoriously difficult. Several issues arise as biomass increases:
- Oxygen becomes limiting, disrupting metabolism
- Nutrients are consumed rapidly, creating oscillations in growth rate
- Metabolic by-products accumulate, altering cell behaviour
- Optical density measurements become fluctuating, making monitoring less accurate
The last point is particularly important:
At high cell density, optical signals behave unpredictably due to light scattering, which means traditional OD₆₀₀ measurements no longer scale linearly. If biomass can’t be measured accurately, it can’t be controlled accurately.
Modern turbidostats solve this issue using in-situ biomass probes paired with appropriate calibration models — a crucial component of any reliable continuous cultivation workflow.
Modern Bioreactor Systems Make Turbidostat Operation Easier
In the past, turbidostats typically required complex custom setups, external hardware, and manual integration. Today, commercially available platforms like the BioXplorer 100 and 400 offer:
- Built-in optical biomass monitoring (BioVIS)
- Automated dilution control via WinISO software
- Parallel bioreactor operation for screening and optimisation
- Flexible working volumes for different scales of development

BioXplorer 100
This means laboratories can establish continuous cultivation and maintain high-density growth, without designing a system from scratch, by integrating parts from several providers
The result is a single platform that supports:
- Process development
- Strain optimization
- Adaptive evolution
- High-value biomolecule production
- Physiology and metabolism research
All with reproducible and stable culture conditions.
Why Accurate Biomass Calibration Matters for Turbidostat Operation
The heart of any turbidostat is the ability to measure biomass in real time. But because optical signals become fluctuating and unpredictable at high density, calibration is essential.
When paired with automated control software, this enables the turbidostat to:
- Stay locked to a defined biomass setpoint
- Respond quickly to changes in growth rate
- Avoid runaway cultures
- Maintain steady-state conditions for long durations
For laboratories aiming to achieve high cell densities with any microbial host (E. coli, B. subtilis, P. pastoris, etc.) , robust calibration is the difference between consistent success in yield production and unstable runs.
Applications That Benefit Most from Turbidostat Operation
A wide range of workflows can be significantly improved through continuous, controlled biomass growth:
Strain Development and Engineering – Stable and reproducible culture conditions facilitate the isolation of the impact of genetic modifications.
High Cell Density Fermentation – A useful technique for recombinant protein expression and metabolite production.
Adaptive Laboratory Evolution – Continuous, steady-state environments enable consistent application of selective pressures.
Comparative Physiology Studies – Consistent biomass removes confounding variables.
Bioprocess Optimisation and Scale-Up – Parallel turbidostat bioreactors allow rapid screening of strains, growth conditions, or media formulations.
If reproducibility and high-density growth are priorities, turbidostat operation is often the most effective approach.
The BioXplorer Platform: Lowering the Barrier to Continuous Cultivation
The BioXplorer 100 and 400 systems make high cell density turbidostat operation accessible by combining:
- In-situ optical density measurements (BioVIS)
- Automated dilution control
- Parallel reactor formats
- Flexible working volumes
- Comprehensive data capture via WinISO
For teams exploring continuous microbial cultivation, these features offer a streamlined path to consistent, reliable, and reproducible growth.

BioXplorer 400P
The BioXplorer 400P extends the offering further, enabling pressurised bioprocessing for specialist applications.
Conclusion
Modern systems that can operate as turbidostats, have transformed the way researchers cultivate microorganisms, making it easier than ever to maintain stable, high cell density growth conditions. With integrated optical monitoring, automated control, and scalable parallel designs, the BioXplorer platform series helps teams achieve:
- Reliable steady-state cultures
- More reproducible data
- Higher productivity
- Greater experimental confidence
Whether you’re optimizing a fermentation process, developing new strains, or running long-term studies, adopting a turbidostat approach can significantly improve results.







